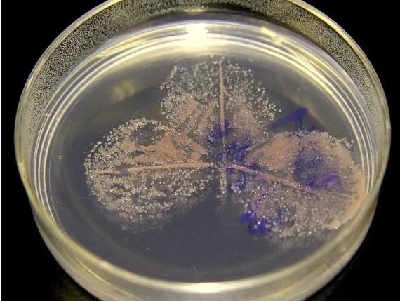
Nghiên cứu sản xuất thành phần proten thay thế bột cá

Sau thu hoạch
-
Phát triển công nghiệp sinh học: Đa dạng sản phẩm chế biến từ thủy sản Việt Nam Việt Nam có tiềm năng xuất khẩu thủy sản rất lớn với doanh thu gần 10 tỷ USD/năm. Chế biển thủy sản trong nước mới chỉ chủ yếu tập trung chế biến thô, công nghệ chế biến sâu chưa được quan tâm phát triển. Bên cạnh đó, chế biến thủy sản trong nước chủ yếu chú trọng phục vụ chế biến thực phẩm, trong khi đó tiềm năng phát triển trong lĩnh vực y dược và một số lĩnh vực khác chưa được khai thác. ... -
Kiểm tra định kỳ kết quả các nhiệm vụ KH&CN thuộc Đề án Phát triển và ứng dụng CNSH trong lĩnh vực công nghiệp chế biến đến năm 2020 Sáng ngày 29/5/2019, tại Viện nghiên cứu Hải sản, ông Nguyễn Việt Nghĩa, Phó Viện trưởng đại diện Ban Lãnh đạo Viện tiếp đoàn kiểm tra định kỳ của Bộ Công Thương kiểm tra định kỳ kết quả 02 nhiệm vụ sản xuất thử nghiệm thuộc Đề án Phát triển và ứng dụng CNSH trong lĩnh vực công nghiệp chế biến đến năm 2020. Nhiệm vụ (1) “Sản xuất một số thực phẩm chức năng từ cá nóc Việt Nam”, Mã số: SXTN.02.CNSHCB do KS. Vũ Xuân Sơn làm Chủ nhiệm và nhiệm vụ (2) “Hoàn thiện công nghệ sản xuất thức ăn nuôi thủy sản giàu lysine từ phế phụ phẩm cá tra”, Mã số: SXTN.05.19.CNSHCB do TS. Nguyễn Hữu Hoàng làm Chủ nhiệm. ... -
Nghiệm thu Quy trình Công nghệ bảo quản cá ngừ đại dương trên tàu câu cá ngừ vỏ gỗ công suất ≥ 400 CV bằng đá sệt Chiều ngày 27/5/2020, Hội đồng Khoa học và Đào tạo Viện nghiên cứu Hải sản tổ chức nghiệm thu “Quy trình Công nghệ bảo quản cá ngừ đại dương trên tàu câu cá ngừ vỏ gỗ công suất ≥ 400 CV bằng đá sệt” thuộc đề tài cấp Bộ “Nghiên cứu ứng dụng hệ thống thiết bị bảo quản cá ngừ đại dương bằng đá sệt trên tàu vỏ gỗ” do TS. Nguyễn Xuân Thi làm Chủ nhiệm. ... -
Nghiên cứu xây dựng quy trình sản xuất bột thịt xương và mùn hữu cơ từ phế phụ phẩm thực phẩm Sáng 15/05/2020, Sở Khoa học và Công nghệ thành phố Hải Phòng tổ chức Hội nghị tư vấn đánh giá, nghiệm thu kết quả thực hiện đề tài nghiên cứu khoa học cấp thành phố: “Nghiên cứu xây dựng quy trình sản xuất bột thịt xương và mùn hữu cơ từ phế phụ phẩm thực phẩm”. Đề tài do Kỹ sư Nguyễn Văn Thành, Nghiên cứu viên Phòng Nghiên cứu công nghệ sau thu hoạch, Viện nghiên cứu Hải sản làm chủ nhiệm. ... -
Hội nghị giải pháp nâng cao hiệu quả khai thác, chế biến, tiêu thụ hải sản năm 2020 Ngày 16/05/2020 tại Phú Yên, Bộ Nông nghiệp và Phát triển nông thôn đã phối hợp với UBND tỉnh Phú Yên tổ chức “Hội nghị giải pháp nâng cao hiệu quả khai thác, chế biến, tiêu thụ hải sản năm 2020”. Chủ trì Hội nghị gồm có: ông Phùng Đức Tiến, Thứ trưởng Bộ Nông nghiệp và Phát triển nông thôn; ông Trần Hữu Thế, Phó Chủ tịch UBND tỉnh Phú Yên và ông Nguyễn Quang Hùng, Phó tổng Cục trưởng Tổng cục Thuỷ sản. Hội nghị còn có sự tham dự của các cơ quan trực thuộc Tổng cục Thuỷ sản, Viện nghiên cứu Hải sản, Cục quản lý chất lượng Nông lâm và Thủy sản, Sở Nông nghiệp và Phát triển nông thôn, Chi cục Thủy sản các tỉnh ven biển, Hội nghề cá Việt Nam,… ... -
Hội thảo góp ý cho Bộ tiêu chí đánh giá tổn thất sau thu hoạch sản phẩm trên tàu khai thác xa bờ Ngày 19/12/2019, Viện nghiên cứu Hải sản đã tổ chức Hội thảo góp ý cho Bộ tiêu chí đánh giá tổn thất sau thu hoạch sản phẩm trên tàu khai thác xa bờ thuộc đề tài “ Nghiên cứu đánh giá mức độ tổn thất sản phẩm sau thu hoạch của tàu khai thác xa bờ (nghề chụp, lưới vây, lưới rê, kéo đôi, câu cá ngừ đại dương)do TS. Bùi Thị Thu Hiền làm Chủ nhiệm. Tới dự Hội thảo về phía cơ quan quản lý có Cục Chất lượng Nông lâm thủy sản; Chi cục Quản lý chất lượng nông lâm thủy sản Hải Phòng; Sở Khoa học Công nghệ Hải Phòng; và các chuyên gia trong lĩnh vực Công nghệ sinh học, Quản lý chất lượng, Công nghệ thực phẩm, Đánh giá chất lượng; PGS.TS Đỗ Văn Khương chủ trì Hội thảo. ... -
Tọa đàm Xây dựng Đề án Công nghiệp sinh học đến năm 2030 và kế hoạch triển khai thực hiện đề án Sáng ngày 06/9/2019, Viện nghiên cứu Hải sản tổ chức Tọa đàm Xây dựng Đề án Công nghiệp sinh học (CNSH) đến năm 2030 và kế hoạch triển khai thực hiện đề án. Tham dự tọa đàm có Đoàn công tác của Bộ Công thương: TS. Đặng Tất Thành làm Trưởng đoàn; Chuyên gia: TS. Nguyễn Quang Thảo; PGS. TS Chu Kỳ Sơn – Viện trưởng Viện Công nghệ sinh học và Công nghệ thực phẩm, Đại học Bách khoa Hà Nội; PGS.TS Phí Quyết Tiến – Phó Viện trưởng Viện Công nghệ sinh học, Viện Hàn lâm khoa học và Công nghệ Việt Nam; PGS. TS Vũ Nguyên Thành – Phó Viện trưởng Viện Công nghệ thực phẩm; PGS. TS. Trần Hoàng Dũng – Đại học Nguyễn Tất Thành. Về phía Viện nghiên cứu Hải sản có Ông Nguyễn Viết Nghĩa - Phó Viện trưởng, Bà Đặng Thị Minh Thu – Phó Trưởng Phòng KH, HTQT& ĐT; TS. Bùi Thị Thu Hiền – Q. Trưởng phòng Phòng nghiên cứu Công nghệ Sau thu hoạch cùng các cán bộ chủ chốt của Viện. Tham dự Tọa đàm còn có các đại biểu đại diện đến từ các đơn vị khác nhau như: TS. Trịnh Thành Trung - Viện trưởng, Viện Vi sinh vật và Công nghệ Sinh học - Đại học Quốc gia Hà Nội; TS. Phạm Đức Thuận: Viện trưởng - Viện Công nghệ sinh học và Hóa dược Novaco (Novains); TS. Phạm Kiên Cường- Trưởng phòng Công nghệ Hóa sinh, Viện Công nghệ mới, Bộ Quốc Phòng; TS. Trần Mạnh Hà, Viện Tài nguyên và Môi trường Biển; Bà Nguyễn Thu Hồng – Giám đốc Công ty Canafood Nha Trang, Ông Đỗ Ngọc Vinh – Giám đốc Công ty TNHH MTV Minh Quang - Quảng Ngãi. ... -
Phạt tiền tới 100 triệu đồng đối với các hành vi thu gom, mua bán, lưu giữ, sơ chế, chế biến, bảo quản, vận chuyển trái phép thủy sản Ngày 16/5/2019, Chính phủ đã ban hành Nghị định số 42/2019/NĐ-CP quy định xử phạt vi phạm hành chính trong lĩnh vực thủy sản; Trong đó có các quy định về hành vi vi phạm và các mức xử phạt hành vi vi phạm về thu gom, mua bán, lưu giữ, sơ chế, chế biến, bảo quản, vận chuyển thủy sản. ... -
Hội nghị nghiệm thu cấp Nhà nước Dự án “Sản xuất một số sản phẩm thực phẩm từ nhuyễn thể bằng công nghệ sinh học” Ngày 20/6//2019 Bộ Công thương đã tổ chức Hội nghị nghiệm thu đánh giá cấp Nhà nước, Dự án “Sản xuất một số sản phẩm thực phẩm từ nhuyễn thể bằng công nghệ sinh học” thuộc Đề án phát triển và ứng dụng công nghệ sinh học trong lĩnh vực công nghiệp chế biến đến năm 2020, do Th.S Vũ Thị Quyên làm Chủ nhiệm. Hội đồng nghiệm thu gồm các chuyên gia đầu ngành thuộc lĩnh vực Công nghệ Sinh học. ... -
Nghiên cứu sản xuất thành phần proten thay thế bột cá KnipBio đã thông báo rằng giờ đây họ có thể sản xuất thành phần protein thức ăn nuôi trồng thủy sản đơn bào, KnipBio Meal (KBM), từ các chất hòa tan của máy chưng cất (CDS). ... -
V/v xin ý kiến góp ý Dự thảo TCVN Quy trình bảo quản sản phẩm khai thác hải sản xa bờ ... -
Nghiên cứu xây dựng quy trình công nghệ chế biến một số sản phẩm từ hàu Crassostrea gigas Thunberg, 1793 Chiều ngày 10/5/2016 Viện nghiên cứu Hải sản tổ chức Hội thảo liên ngành góp ý báo cáo tổng kết đề tài cấp thành phố “Nghiên cứu xây dựng quy trình công nghệ chế biến một số sản phẩm từ hàu Crassostrea gigas Thunberg, 1793” do ThS. Trần Thị Ngà làm Chủ nhiệm. ... -
Danh mục các loài hải sản kinh tế thường gặp ở vùng biển xa bờ Các loài hải sản kinh tế thường gặp ở vùng biển xa bờ ... -
Hướng dẫn nhận biết cá an toàn và không an toàn Tài liệu viện dẫn (1): Cá tươi chất lượng và các biến đổi về chất lượng, FAO tài liệu kỹ thuật thủy sản, NXB Nông nghiệp 2004. (2) Đánh giá độ tươi: Qui chế của Hội đồng (EEC) No. 103/76 OJ No.L20 (28-01-1976) (EEC,1976). (3) Phương pháp cảm quan thủy sản theo TCVN 5277-1990 (4) Sản phẩm thực phẩm phân tích cảm quan theo phương pháp cho điểm TCVN 3215-79 (5) 58 TCN 9 – 1974: Cá tươi tự nhiên- yêu cầu kỹ thuật (6) TCVN 2646-1978: Cá biển ướp nước đá- yêu cầu Kỹ thuật ... -
Nghiệm thu cơ sở đề tài KHCN cấp quốc gia Nghiệm thu cơ sở đề tài khoa học công nghệ cấp quốc gia “Nghiên cứu ứng dụng công nghệ enzyme để sản xuất bột đạm thủy phân giàu axits amin từ moi và cá nục ứng dụng trong sản xuất nước mắm công nghiệp" ...

.jpg)













